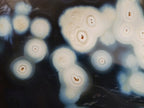
Polished Snow Orca Agate Standing Free Forms x 2 From West Coast, Madagascar

Welcome to TOPROCKS.COM - You are shopping on our RETAIL site for worldwide customers and collectors. You are welcome to Shop and Ship any of our 20,000+ specimens with no minimum requirements. For WHOLESALE access, please Login using your 'Approved Wholesale / Trade' email address (HOW?) or email Renate@Toprocks.com

Polished Snow Orca Agate Standing Free Forms x 2 From West Coast, Madagascar
RETAIL PRICE
A NOTE FROM NICK
New Stock!! A Pair of Polished Snow Orca Agate Standing Display Pieces. Nice!
PRODUCT DESCRIPTION
Snow / Orca Agate From West Coast Madagascar
Snow / Orca Agate from Madagascar is a unique variety of Agate characterized by its striking patterns of black, grey, and white, resembling the markings of an Orca Whale. This agate often displays swirling or banded designs, with snow-like patches of white against a darker background.
PRODUCT MINERALS
Silicon Dioxide, Chalcedony, Manganese Iron
PRODUCT FEATURES
Trigonal,
PRODUCT COLOUR
Black, White
MOHS HARDNESS SCALE
6.5 - 7
PRODUCT DATA
Locality = West Coast, Madagascar
Grade = Very Good to A Grade
Size = 129 - 160 mm